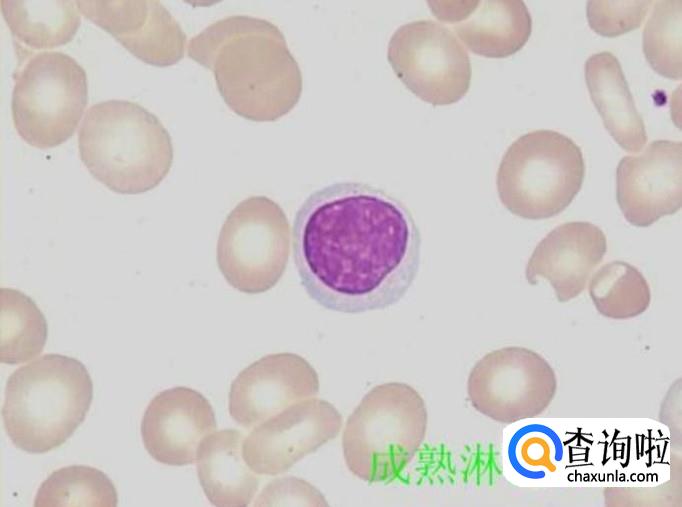
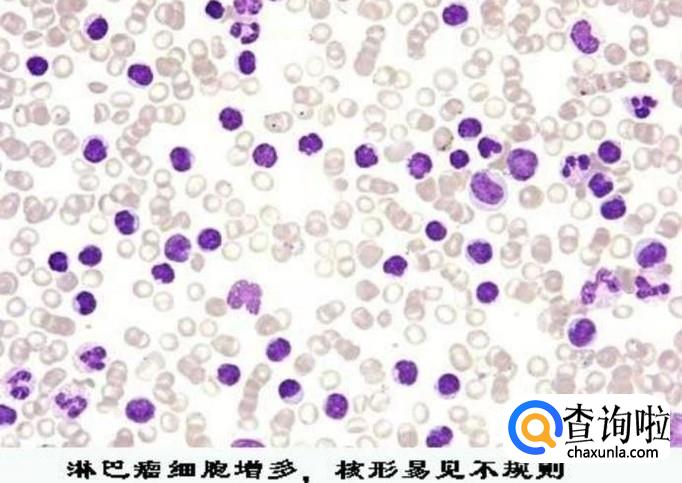

最佳回答
本文由作者推荐
详细内容
- 01
淋巴细胞的正常百分比参考值在20%到40%之间。超过40%属于淋巴细胞比值偏高。淋巴细胞比值占白细胞总数的20%到30%之间,分为T细胞、B细胞、杀伤细胞和自然杀伤细胞等四大类。T细胞约占75%,参与细胞免疫,B细胞约占10%到15%,参与体液免疫。
- 02
当我们的机体被病毒感染时,我们的淋巴细胞数量就会增加,相应的淋巴细胞的比值也会随之增高。
- 03
还有当我们患某些传染性疾病的时候,体内的淋巴细胞也会增多,导致淋巴细胞比值升高。例如水痘、病毒性肝炎,流行性腮腺炎等一系列传染性疾病。

- 04
淋巴细胞就是一种免疫细胞,当我们发身体现淋巴细胞数量增多,比值偏高时,就说明我们的身体处于一个免疫力低下时期,容易被病毒感染,我们应该注意自己的身体状况,增强免疫力。但是不要自己盲目服药,要遵从医嘱,积极预防疾病。

广告位
点击排行
- 2 排行
- 3 排行
- 4 排行
- 5 排行
- 6 排行
- 7 排行
- 8 排行
- 9 排行
- 10 排行
热点追踪
广告位





















